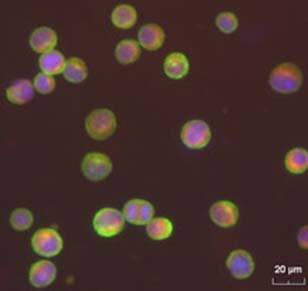

..فوضى الحواس..
•
ماحولي احد !!!!!!!!!!!!!!!!!!!!!!!!!!!!!!!!!!!!!!
تحذير يابنات :
تراه خطير على الصحة
تقرير: مادة الفينيل أخطر المواد البلاستيكية تسببًا للسرطان والتشوهات الخلقية
http://www.islammemo.cc/akhbar/Oloom.../06/62067.html
تقرير: مادة الفينيل أخطر المواد البلاستيكية تسببًا للسرطان والتشوهات الخلقية
الاثنين 07 ابريل 2008
مفكرة الاسلام: في الآونة الأخيرة أظهرت الدراسات والتجارب أثر بعض المواد البلاستيكية على صحة الانسان وعلى البيئة بشكل عام, ما استدعى ضرورة التعامل مع المواد البلاستيكية بحذر شديد للحفاظ على صحة الإنسان والكائنات الحية الأخرى والبيئة من تلك الأضرار والآثار الملوثة الناتجة عنها.
فمنذ بدأ انتاج المواد البلاستيكية أول مرة بصورة تجارية في عام 1869 أدى ذلك إلى فتح الباب على مصراعيه لتطوير تلك الصناعة في العديد من المجالات وفي كافة مناحي الحياة لتحل بديلاً للعديد من المواد الخام الأخرى التي اعتاد الإنسان على استخدامها لقرون عديدة, كالقطن والصوف والحرير والجلود وغيرها.
وقالت دراسة أعدها فريق من المختصين تابع لجمعية البيئة والحياة البريطانية نشرت حديثًا على موقع الجمعية في الإنترنت: إن تعامل الأفراد بصفة يومية مع المواد البلاستيكية شديدة الثبات وعالية المقاومة للتحلل البيئي أضحى جزءًا ضروريًا في حياة الإنسان العصرية.
وأضافت الدراسة أن من أخطر المواد البلاستيكية تلك المصنوعة من مادة (الفينيل) التي تحتوي على (الكلوريد) الذي يدخل في صناعة بطاقات الائتمان وخراطيم المياه وحقائب اليد وألعاب الأطفال القابلة للنفخ, مثل البالونات والكرات البلاستيكية, حيث تكمن خطورة تلك المادة في كونها مسببًا لأمراض السرطان والتشوهات الخلقية والتغيرات الجينية والالتهاب الشعبي المزمن والقرحة, إضافة إلى أمراض جلدية أخرى.
وأشارت إلى أن وزارة الصحة البريطانية لاحظت ارتفاعًا في عدد الوفيات من الأطفال الرضع لدى الطبقات الفقيرة, حيث أثبتت التحقيقات أن ذلك يرجع إلى استخدام مفارش مستعملة مصنوعة من الإسفنج, الذي يدخل في تركيبه الألياف البلاستيكية والتي ينتج عنها مواد متطايرة إثر استهلاك تلك المفارش, ما يسبب اختناقًا للأطفال أثناء النوم, ما دعا الوزارة إلى منع تداول هذه النوعية من المراتب وسحبها من الأسواق.
وأضافت أن أضرارالمواد البلاستيكية لا تقتصر على الأطفال فحسب, فالنصيب الأكبر للبالغين, فاستنشاق بخار البلاستيك عن طريق بعض الملابس التي تدخل في صناعتها مادة (البوليستر) أو الوجبات السريعة المشبعة بتلك الأبخرة نتيجة حفظها في علب بلاستيكية تجعل الإنسان عرضة لتلك المخاطر بشكل يومي.
وأوضحت أن تلك الألياف تسبب تهيجًا في العين والجهاز التنفسي وطفحًا جلديًا حادًا عند البعض ممن يعانون حساسية من تلك المواد الموجودة في الملابس والبطانيات وأقمشة تنجيد الأثاث.
وركزت على أسوأ أنواع مخاطر المواد البلاستيكية الذي يتمثل في الغازات الناجمة عن اإحتراق تلك المواد, كونها سريعة الاشتعال وذات حرارة مرتفعة, حيث أشارت إلى أن ما يربو على 80% من المتضررين هم ممن استنشقوا تلك الغازات المنبعثة من حرائق المواد البلاستيكية.
وتوضح الدراسة أن خطورة البلاستيك امتدت إلى أبعد من ذلك لتصل إلى البحار والأسماك, حيث أشارت الدراسة إلى أن وزن النفايات الصلبة التي تلقى في البحار والمحيطات يبلغ 14 مليار طن سنويًا يمثل البلاستيك 10% منها.
وتتمثل أخطار تلك المواد على البيئة البحرية في خيوط الألياف البلاستيكية التي تعمل على سد خياشيم التنفس للأسماك, ما يؤدي إلى نفوق جماعي لهذه الأسماك أو نخفاض القيمة الغذائية نتيجة ابتلاع الأسماك لتلك المواد.
وأشارت إلى أن الشعاب المرجانية لم تنجُ من خطر التلوث بالمواد البلاستيكية, حيث تتراكم تلك النفايات على الشعب لتمنع وصول أشعة الشمس والتيارات المائية المتجددة الداخلة والخارجة منها وإليها, والتي تحمل لها الطعام والأكسجين, ما يؤدي إلى موت تلك الكائنات التي تعد عاملاً رئيسًا في التوازن البيئي في البحار والمحيطات.
وحول كيفية تقليل هذه المخلفات أشارت الدراسة إلى ضرورة العمل على إيجاد بدائل عن المواد البلاستيكية كالورق أو المواد الأخرى القابلة للتدوير.
يذكر أن النفط والغاز يشكلان العنصرين الرئيسين لتركيب المواد البتروكيماوية اللازمة لإنتاج المواد البلاستيكية المختلفة التي يستخدمها الإنسان بشكل يومي في حياتنا المعاصرة.
تراه خطير على الصحة
تقرير: مادة الفينيل أخطر المواد البلاستيكية تسببًا للسرطان والتشوهات الخلقية
http://www.islammemo.cc/akhbar/Oloom.../06/62067.html
تقرير: مادة الفينيل أخطر المواد البلاستيكية تسببًا للسرطان والتشوهات الخلقية
الاثنين 07 ابريل 2008
مفكرة الاسلام: في الآونة الأخيرة أظهرت الدراسات والتجارب أثر بعض المواد البلاستيكية على صحة الانسان وعلى البيئة بشكل عام, ما استدعى ضرورة التعامل مع المواد البلاستيكية بحذر شديد للحفاظ على صحة الإنسان والكائنات الحية الأخرى والبيئة من تلك الأضرار والآثار الملوثة الناتجة عنها.
فمنذ بدأ انتاج المواد البلاستيكية أول مرة بصورة تجارية في عام 1869 أدى ذلك إلى فتح الباب على مصراعيه لتطوير تلك الصناعة في العديد من المجالات وفي كافة مناحي الحياة لتحل بديلاً للعديد من المواد الخام الأخرى التي اعتاد الإنسان على استخدامها لقرون عديدة, كالقطن والصوف والحرير والجلود وغيرها.
وقالت دراسة أعدها فريق من المختصين تابع لجمعية البيئة والحياة البريطانية نشرت حديثًا على موقع الجمعية في الإنترنت: إن تعامل الأفراد بصفة يومية مع المواد البلاستيكية شديدة الثبات وعالية المقاومة للتحلل البيئي أضحى جزءًا ضروريًا في حياة الإنسان العصرية.
وأضافت الدراسة أن من أخطر المواد البلاستيكية تلك المصنوعة من مادة (الفينيل) التي تحتوي على (الكلوريد) الذي يدخل في صناعة بطاقات الائتمان وخراطيم المياه وحقائب اليد وألعاب الأطفال القابلة للنفخ, مثل البالونات والكرات البلاستيكية, حيث تكمن خطورة تلك المادة في كونها مسببًا لأمراض السرطان والتشوهات الخلقية والتغيرات الجينية والالتهاب الشعبي المزمن والقرحة, إضافة إلى أمراض جلدية أخرى.
وأشارت إلى أن وزارة الصحة البريطانية لاحظت ارتفاعًا في عدد الوفيات من الأطفال الرضع لدى الطبقات الفقيرة, حيث أثبتت التحقيقات أن ذلك يرجع إلى استخدام مفارش مستعملة مصنوعة من الإسفنج, الذي يدخل في تركيبه الألياف البلاستيكية والتي ينتج عنها مواد متطايرة إثر استهلاك تلك المفارش, ما يسبب اختناقًا للأطفال أثناء النوم, ما دعا الوزارة إلى منع تداول هذه النوعية من المراتب وسحبها من الأسواق.
وأضافت أن أضرارالمواد البلاستيكية لا تقتصر على الأطفال فحسب, فالنصيب الأكبر للبالغين, فاستنشاق بخار البلاستيك عن طريق بعض الملابس التي تدخل في صناعتها مادة (البوليستر) أو الوجبات السريعة المشبعة بتلك الأبخرة نتيجة حفظها في علب بلاستيكية تجعل الإنسان عرضة لتلك المخاطر بشكل يومي.
وأوضحت أن تلك الألياف تسبب تهيجًا في العين والجهاز التنفسي وطفحًا جلديًا حادًا عند البعض ممن يعانون حساسية من تلك المواد الموجودة في الملابس والبطانيات وأقمشة تنجيد الأثاث.
وركزت على أسوأ أنواع مخاطر المواد البلاستيكية الذي يتمثل في الغازات الناجمة عن اإحتراق تلك المواد, كونها سريعة الاشتعال وذات حرارة مرتفعة, حيث أشارت إلى أن ما يربو على 80% من المتضررين هم ممن استنشقوا تلك الغازات المنبعثة من حرائق المواد البلاستيكية.
وتوضح الدراسة أن خطورة البلاستيك امتدت إلى أبعد من ذلك لتصل إلى البحار والأسماك, حيث أشارت الدراسة إلى أن وزن النفايات الصلبة التي تلقى في البحار والمحيطات يبلغ 14 مليار طن سنويًا يمثل البلاستيك 10% منها.
وتتمثل أخطار تلك المواد على البيئة البحرية في خيوط الألياف البلاستيكية التي تعمل على سد خياشيم التنفس للأسماك, ما يؤدي إلى نفوق جماعي لهذه الأسماك أو نخفاض القيمة الغذائية نتيجة ابتلاع الأسماك لتلك المواد.
وأشارت إلى أن الشعاب المرجانية لم تنجُ من خطر التلوث بالمواد البلاستيكية, حيث تتراكم تلك النفايات على الشعب لتمنع وصول أشعة الشمس والتيارات المائية المتجددة الداخلة والخارجة منها وإليها, والتي تحمل لها الطعام والأكسجين, ما يؤدي إلى موت تلك الكائنات التي تعد عاملاً رئيسًا في التوازن البيئي في البحار والمحيطات.
وحول كيفية تقليل هذه المخلفات أشارت الدراسة إلى ضرورة العمل على إيجاد بدائل عن المواد البلاستيكية كالورق أو المواد الأخرى القابلة للتدوير.
يذكر أن النفط والغاز يشكلان العنصرين الرئيسين لتركيب المواد البتروكيماوية اللازمة لإنتاج المواد البلاستيكية المختلفة التي يستخدمها الإنسان بشكل يومي في حياتنا المعاصرة.
ويهـــاد
•
شوووووووووووووووووووووووي عليه كلمة رووووووووووووووعه بصراحه حلو مره وتنظيفه سهل مره
ولا يبين فيه الكعب بس الأثاث ممكن بس بعد فتره يروح الأثر
أنظفه بمويه وومكن بمويه وصابون يصير يبرق
بس مشكلته تزحلقين فيه على طول إذا جاء فيه مويه
زيه زي السيراميك
أحلى شيء فيه إذا بغيتي تغيرين على طول تشيلينه وتغيرين ما يأخذ وقت
ولا يجي فيه ريحه ولا حتى نمل ولا صراصير مررررررررررررررره روووووووووووووووووووعه
نسيت أقولكم ألي عندي ألماني
وله 8 سنوات ما تغير
ولا يبين فيه الكعب بس الأثاث ممكن بس بعد فتره يروح الأثر
أنظفه بمويه وومكن بمويه وصابون يصير يبرق
بس مشكلته تزحلقين فيه على طول إذا جاء فيه مويه
زيه زي السيراميك
أحلى شيء فيه إذا بغيتي تغيرين على طول تشيلينه وتغيرين ما يأخذ وقت
ولا يجي فيه ريحه ولا حتى نمل ولا صراصير مررررررررررررررره روووووووووووووووووووعه
نسيت أقولكم ألي عندي ألماني
وله 8 سنوات ما تغير
الصفحة الأخيرة